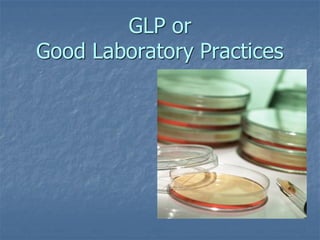

The document discusses Good Laboratory Practices (GLP), which are regulations created by the FDA in 1978 that provide a framework for conducting laboratory studies. GLP aims to ensure data submitted to regulatory authorities is accurate and traceable. The FDA investigation of laboratories in the 1970s uncovered fraudulent activities and poor practices that led to the creation of GLP. Key aspects of GLP include standard operating procedures, personnel qualifications, facility organization, equipment validation and maintenance of complete records. Noncompliance with GLP can result in the disqualification of a testing facility.